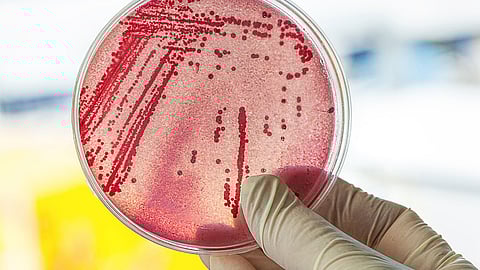
ஆய்வு சோதனை

சென்னை: குடிநீரில் 75% E coli பாக்டீரியா: IIT மெட்ராஸ் எச்சரிக்கை
சென்னை மக்களில் 75% வீடுகளில் உபயோகிக்கப்படும் குடிநீரில் டயரியாவை ஏற்படுத்தும் E coli பாக்டீரியா இருப்பதாக சென்னை ஐஐடி எச்சரித்துள்ளது.
சென்னையைப் பொறுத்தவரை குடிநீர் பற்றாக்குறை என்பது நாளுக்குநாள் அதிகரித்து வருகிறது. குடிநீர் பற்றாக்குறையை நீக்குவதற்காக சென்னை மக்கள் குடிநீரை விலைகொடுத்து வாங்கியும், சிலர் சுத்திகரிக்கப்பட்ட குடிநீரையும் பயன்படுத்தி வருகின்றனர். இந்த குடிநீரானது சுகாதாரமாக இருக்கிறதா என்பதை பற்றி அவர்கள் தெரிந்திருக்கவில்லை.
சமீபத்தில் சென்னை ஐஐடி ஆய்வாளர்கள் மற்றும் மாணவர்கள் குடிநீரின் தரத்தினை அறிந்துகொள்ள ஒரு ஆய்வினை மேற்கொண்டனர். இதன்படி சென்னைப்பகுதிகளிலிருந்து சுமார் 752 வீடுகளில் உபயோகிக்கப்படும் நீரினை சேகரித்து ஆய்வு மேற்கொண்டதில், சேகரிக்கப்பட்ட குடிநீரில் 75% தண்ணீரில் E coli என்ற உடலுக்கு தீங்கிழைக்கும் பாக்டீரியா கலந்து இருப்பதாக அதிர்ச்சி தரும் தகவலை தெரிவித்துள்ளனர்.
தண்ணீர் கேன் , தண்ணீர் டேங்குகளில் சேகரிக்கப்பட்டிருக்கும் நீர் அல்லது குடிநீர் தொட்டியிலிருந்து பெறப்படும் தண்ணீரில் E coli பாக்டீரியா கலந்து இருக்கும், ஆனால், வீடுகளில் சுத்திகரிப்பான்களைப்பயன்படுத்தி சுத்தமான குடிநீரை பெறுகிறோம். அதில் பாக்டீரியா கலந்திருக்க வாய்ப்பில்லை என்று நீங்கள் நினைத்தால்... அது தவறு...
இதைப்பற்றி ஐஐடி மெட்ராஸின் நீர்தரத் திட்டத்தின் பாட ஒருங்கிணைப்பாளர்களில் ஒருவரான சுசான் ககன் என்பவர், பிரபல பத்திரிகையில் பேட்டி ஒன்றைக் கொடுத்துள்ளார். அதில், ”தண்ணீர் சுத்திகரிப்பான்களைப் பயன்படுத்துவர்கள் கூட எப்போதும் பாதுகாப்பான மற்றும் சுத்தமான குடிநீரை குடிப்பதில்லை. அதிலும் பாக்டீரியா கலந்துள்ளது ” என்ற தகவலை தெரிவித்துள்ளார்.
ஆக, சுத்திகரிப்பான் மூலம் பெறப்படும் தண்ணீரிலும் E coli பாக்டீரியா கலந்துள்ளது என்பது அதிர்ச்சியளிக்கும் செய்தியாக இருக்கிறது.
ஆய்வாளர்கள் ஆய்வுக்காக தேர்ந்தெடுக்கப்பட்ட குடும்பங்களில், 75 % குடும்பங்களில் பல சிறு குழந்தைகள் இருக்கின்றார்கள் என்றும், இதில் 5 வயதுக்குட்பட்ட குழந்தைகளில் 58% சதவிகித குழந்தைகள் நேரடியாக குழாயிலிருந்து வரும் தண்ணீரை உபயோகப்படுத்துகிறார்கள் என்றும், 15% சதவிகித மக்கள் சுத்திகரிக்கப்பட்ட நீர் அமைப்புகளிலிருந்து பெறப்படுகின்ற குடிநீரை உபயோகப்படுத்துகிறார்கள் என்றும் தெரிவிக்கின்றனர்.
தடுப்பது எப்படி?
தற்பொழுது மழைக்காலம் ஆரம்பித்த நிலையில், கை, கால்கள் சுத்தமாக இருப்பதுடன், சுத்திகரிக்கப்பட்ட குடிநீர் என்றாலும், அதை நன்கு கொதிக்கவைத்து வடிகட்டி பின் உபயோகப்படுத்தி வந்தால், நோய் அண்டுவது குறையக்கூடும், மேலும் குழந்தைகளுக்கு வயிற்றுப்போக்கு, வாந்தி பேதி வந்தால் உடனடியாக மருத்துவரை அணுகி அதற்கான சிகிச்சை முறையை மேற்கொள்ளவேண்டும் என்றும் கூறப்படுகிறது.